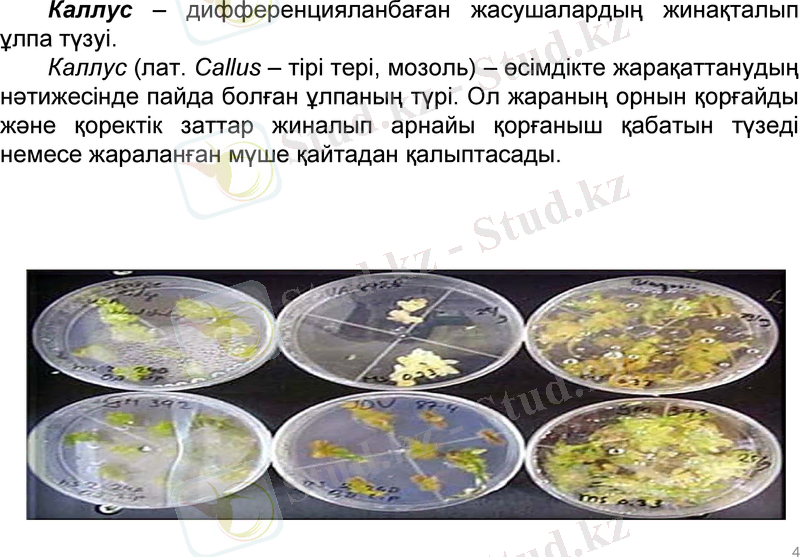
Slide 4

Каллус клеткаларын алу және in vitro өсіру: өсімдік ұлпаларын культивациялау әдістері мен морфогенез негіздері



Каллус клеткаларын алу және өсіру
Алматы - 2017 жыл

Өзектілігі: Каллус клеткаларын алу және өсірумен толық танысу.
Мақсаты: Өсімдіктердің жаңа сорттарын шығаруға қажет селекциялық материалды аз уақыт ішінде алу үшін өсімдік жасушаларын өсіру.
Міндеті: Каллус клеткаларын алуға шолу жасау
2

Өсімдік клеткаларын қолдан өсіру
Өсімдіктің жеке мүшелерін асептикалық жағдайда жасанды қоректік ортада өсіру.
Өсімдік ұлпасының стерилденген кішкене бөлшегін Петри табақшасының немесе пробиканың ішіне агарлы қоректік ортаға орналастырады. Содан кейін ұлпада жасушалар белсенді түрде бөліне бастайды. Жасушалық түзілім тез өсіп каллус түзеді.
3
Каллус - дифференцияланбаған жасушалардың жинақталып ұлпа түзуі.
Каллус (лат. Callus - тірі тері, мозоль) - өсімдікте жарақаттанудың нәтижесінде пайда болған ұлпаның түрі. Ол жараның орнын қорғайды және қоректік заттар жиналып арнайы қорғаныш қабатын түзеді немесе жараланған мүше қайтадан қалыптасады.
4

In vitro термині (лат. - шыныда, әйнекте) стерильді жасанды қоршаған ортада өтетін процестердің жағдайларын сипаттау үшін қолданылады.
5

In vivo (лат. - тіршілікте) организмнің тіршілік процестерінің табиғи ортада өтуі.
Өсімдік-регенерант - асептикалық түрде алынған, тамыры мен өркені қалыптасқан өсімдік, демек in vitro.
6

Тотипатенттілік (лат. totus - барлық, тұтас, potential - күш) - тұтас организмге дейін дамуын қамтамасыз ететін өзіне тән генетикалық ақпаратты сақтап, үйлестіретін жасушаның қасиеті. Әмбебап тотипатенттілік қасиетке өсімдіктің және жануардың ұрықтанған жұмыртқа жасушасы ие. Ал сомалық жасушалардан тотипатенттілік қасиетке тек қана өсімдік жасушалары ғана ие. Қолдан өсірілетін жануарлар жасушасы тотипатенттілік қасиеттен айырылған.
Тотипатенттік қасиет - жасандыжағдайда клетканың өзіне тән генетикалық информациясын толығымен жүзеге асыруы, соның арқасында дифференциялану процесін және тұтас организмнің дамуын қамтамасыз етуі.
Қызметтік мамандануына байланысты өсімдік ұлпалары мен жасушалары арасындағы физиологиялық және құрылымдық ерекшеліктердің пайда болуы дифференциация процесі деп аталады.
Дифференциация ұғымы эмбриондық және меристемалық жасушалардың маманданған жасушаларға айналуын көрсетеді.
7

8

Қоректік ортаның құрамы
Минералды тұздар, көмірсулар, витамиңдер, фитогормондар, амин қышкылдары кіреді
Көмірсутегі ретінде сахароза немесе глюкоза косылады.
Азот коректік ортаға нитрат немесе аммоний түрінде косылады, фосфор - фосфат түрінде, күкірт - сульфат түрінде, темір - хелат немесе әр түрлі түздар түрінде қосылады.
9

10

Суспензионды культура
Сұйық ортада қолдан өсірілген өсімдік жасушысын- суспензионды культура деп атайды.
Жасушалардың суспензионды культурасы салыстырмалы гомогенді жасушалық популяция болып табылады
11

Фитогормондар әсері
Өсімдіктер гормондары - өсімдіктермен өндірілетін және реттеуші функцияларды атқаратын төмен молекулалы органикалық заттар.
Ауксиндер - өсімдіктің сабағы мен дәнінің өсуін, күн сәулесі мол жерге бағыттала өсуін, гравитропизм бойынша тамырлардың төменге бағыттала өсуін қадағалайды.
Цитокининдер - өсімдіктердің жасушаларының бөлінуі мен басқа физиологиялық процестерге жауап береді. Олар жасушалардың көбеюін, сабақ пен тамырдың морфогенезін, хлоропласттардың пайда болуын реттейді, жасушалардың ретті өсуін, жанама сабақтар мен тамырлардың дамуына жауап береді.
Гиббереллиндер - дитерпендік табиғаты бар фитогормондардың тобы. Олар гипокатильдің ұзарып өсуі, гүлдену дәндерінің өсуі мен әртүрлі морфогенетикалық процестерге жауап береді.
Кинетин - каллустан жапырақ пен тамырдың пайда болуын қамтамасыз етеді.
In vitro жағдайда каллустың түзілуі және өсуі ауксин мен цитокининмен реттеледі.
Каллус түзілу үшін 2, 4 Д фитогормоны 2. 5мг/л мөлшерде қажет. Эмбриоидтардың өсуіне 0. 1-2. 0 мг/л фитогормондар əсер етеді.
12

Суспензионды жасушаларды алу
Суспензионды жасушаларды алудың негізгі тәсілі тербелгіштегі сұйық ортада борпылдақ дифференциалданбаған каллусты өсіру болып табылады.
Борпылдақ каллусты арнайы осындай мақсаттар үшін 2, 4-Д және құрамы азайған немесе цитокинині жоқ ортада өсіреді.
Сұйық ортадағы каллусты ұлпалардың бөліктері араластырудың әсерінен жасушаларға және жасушалық агрегаттарға ыдырап алғашқы суспензияны түзеді.
Жасушалардың диссоциясына қоректік ортаның құрамы, аэрация және суспензияны араластыруда әсер етеді.
13

Суспензиядағы клеткаларды өсіру әдістері
14
Клеткаларды сұйык коректік ортада өсірудін негізгі екі әдісі болады:
1) мерзімді өсіру- суспензиядағы клеткаларды өсіру процесі белгілі бір уакыт ішінде жүргізіледі және де бастапқы құйылған қоректік орта жаңартылмай, өз нәрі саркылғанша пайдаланылады.
2) үзіліссіз өсіру- суспензиядағы клеткаларды өсіру процесі үэдіксіз жүргізіледі және де коректік орта ылғи жаңартылып тұрады.

Мол өнім алу бірнеше жолмен қамтамасыз етіледі:
1) клеткалардың көбі өсу процесінің экспоненциалды фазасында бола алады;
2) биомассаны өндіріске ыңғайлы кай кезде болса да суспензиядан бөліп алуға болады;
3) сұйық қоректік орта ағынды болып құйылатындықтан, оның сапасы төмендемейді, нәрі сарқылмайды.
15
Үзіліссіз өсірудің мынадай жүйелері бар:
1) ағынды жабық;
2) ағынды ашық;
3) ағынды-ағынсыз.

Өсімдіктердің in vitro морфогенез жолдары
Өсімдіктердің іn vitro морфогенез жолдары 2 кезеңнен тұрады: 1. Каллустық клетка -маманданбаған клетка жиынтығы. 2. Эмбриоид- маманданған құрылым. Бірінші кезеңнің мақсаты- өсімдік регенераттарын алу: 1) Гистогенез - каллустан каллустың дамуы (ұлпалардың) ; 2) Ризогенез - каллустан тамырдың дамуы; 3) Гемогенез - каллустан жапырақ пайда болуы. Бірақ тамыры болмайды; 4) Гемо-ризогенез - каллустан жапырақ пен тамырдың дамуы. Екінші кезеңде - сомалық эмбриоидтар алу. ІІ реттік эмбриоидтар- каллустан эмбриоид түзеді. Эмбриоидтан жəне Гемо-ризогенезден өсімдік аламыз.
16

17

18

Қорытынды
- Іс жүргізу
- Автоматтандыру, Техника
- Алғашқы әскери дайындық
- Астрономия
- Ауыл шаруашылығы
- Банк ісі
- Бизнесті бағалау
- Биология
- Бухгалтерлік іс
- Валеология
- Ветеринария
- География
- Геология, Геофизика, Геодезия
- Дін
- Ет, сүт, шарап өнімдері
- Жалпы тарих
- Жер кадастрі, Жылжымайтын мүлік
- Журналистика
- Информатика
- Кеден ісі
- Маркетинг
- Математика, Геометрия
- Медицина
- Мемлекеттік басқару
- Менеджмент
- Мұнай, Газ
- Мұрағат ісі
- Мәдениеттану
- ОБЖ (Основы безопасности жизнедеятельности)
- Педагогика
- Полиграфия
- Психология
- Салық
- Саясаттану
- Сақтандыру
- Сертификаттау, стандарттау
- Социология, Демография
- Спорт
- Статистика
- Тілтану, Филология
- Тарихи тұлғалар
- Тау-кен ісі
- Транспорт
- Туризм
- Физика
- Философия
- Халықаралық қатынастар
- Химия
- Экология, Қоршаған ортаны қорғау
- Экономика
- Экономикалық география
- Электротехника
- Қазақстан тарихы
- Қаржы
- Құрылыс
- Құқық, Криминалистика
- Әдебиет
- Өнер, музыка
- Өнеркәсіп, Өндіріс
Қазақ тілінде жазылған рефераттар, курстық жұмыстар, дипломдық жұмыстар бойынша біздің қор #1 болып табылады.



Ақпарат
Қосымша
Email: info@stud.kz